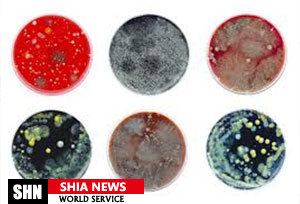

به گزارش «شیعه نیوز»، به نقل از پایگاه اطلاع رسانی پزشکی مدیکال نیوز تودی/medicalnewstoday باکتری کلستریدیوم دیفیسیل که به نام های دیگری نیز خوانده می شود، نوعی باکتری است که موجب التهاب و عفونت در روده می شود. این نوع عفونت عموما بزرگسالان و سالمندان بستری در بیمارستان را مبتلا می کند و معمولا بعد از استفاده از آنتی بیوتیک ها روی می دهد.
پزشکان معتقدند این عفونت یکی از دلایل عمده مرگ و میرهای عفونی است و بیشتر در بیمارستان ها روی می دهد. افرادی که تحت درمان با انواع آنتی بیوتیک هستند با احتمال بیشتر ابتلا و تشدید عفونت یادشده مواجه می شوند؛ زیرا این داروها بر باکتری های طبیعی مستقر در روده تاثیر می گذارند. همچنین استفاده از داروهای ضدالتهاب غیراستروئیدی که درد را کاهش داده و تب و التهاب را پایین می آورند نیز می تواند منجر به آغاز یا افزایش عفونت در بدن شود.
محققان دانشگاه وندربیلت در نشویل آمریکا با همکاری شماری از پژوهشگران دانشگاه میشیگان در آریزونا مطالعه ای را با استفاده از موش های مبتلا به این عفونت انجام داده اند. آنها موش ها را به دو دسته تقسیم و یک دسته را با داروهای ضدالتهاب غیراستروئیدی پیش از ظهور علائم عفونت درمان کردند.
این محققان در پایان دوره مطالعه، مشاهده کردند حدود 20 درصد موش ها در گروهی که داروهای مسکن به آنها داده شده هنوز زنده هستند اما حدود 80 درصد گروهی که درمانی روی آنها انجام نشده سالم هستند.
پژوهشگران با استفاده از نتایج مطالعه یادشده تصمیم گرفتند حتی استفاده محدود از داروهای مسکن قبل از ابتلا به عفونت کلستریدیوم دیفیسیل می تواند شدت عفونت و دوره آن را افزایش و میزان بهبود بیمار را کاهش دهد.
تحلیل های دیگر از این مطالعه نشان می دهد استفاده از این داروها می تواند میکروارگانیسیم های موجود در سیستم گوارش را به نام باکتری های روده تحت تاثیر قرار دهد.
دیوید آرونوف/David Aronoff میکروب شناس و متخصص بیماری های عفونی در دانشگاه وندربلت و محقق سرپرست این مطالعه می گوید: ما همواره دنبال یافتن عوامل خطر قابل تعدیل برای بیماری ها هستیم.
مطالعات این گروه همچنین نشان می دهد داروهای ضدالتهاب غیراستروئیدی به سیستم ایمنی دستگاه گوارش آسیب می رساند، با اینکه داروی آندومتاسین تنها دارویی است که در این مطالعه از آن استفاده شده آرونوف معتقد است یافته های مطالعه همچنین قابل تعمیم و معتبر برای داروهای ضدالتهاب غیراستروئیدی دیگر؛ مانند ایبوپروفن و آسپرین نیز هست. زیرا همه این داروها سازوکار زیستی مشابهی دارند.
وی گفت: این مطالعه می تواند به ما مسیر راه را برای درمان بیماران مبتلا به عفونت نشان دهد به ویژه وقتی باید درد را هم در این بیماران کنترل کنیم. هنوز به آزمایش های بالینی بیشتری نیاز است اما یافته های فعلی می توانند محرک مطالعات بیشتر باشند.

به گزارش «شیعه نیوز»، به نقل از پایگاه اطلاع رسانی پزشکی مدیکال نیوز تودی/medicalnewstoday باکتری کلستریدیوم دیفیسیل که به نام های دیگری نیز خوانده می شود، نوعی باکتری است که موجب التهاب و عفونت در روده می شود. این نوع عفونت عموما بزرگسالان و سالمندان بستری در بیمارستان را مبتلا می کند و معمولا بعد از استفاده از آنتی بیوتیک ها روی می دهد.
به گزارش «شیعه نیوز»، به نقل از پایگاه اطلاع رسانی پزشکی مدیکال نیوز تودی/medicalnewstoday باکتری کلستریدیوم دیفیسیل که به نام های دیگری نیز خوانده می شود، نوعی باکتری است که موجب التهاب و عفونت در روده می شود. این نوع عفونت عموما بزرگسالان و سالمندان بستری در بیمارستان را مبتلا می کند و معمولا بعد از استفاده از آنتی بیوتیک ها روی می دهد.